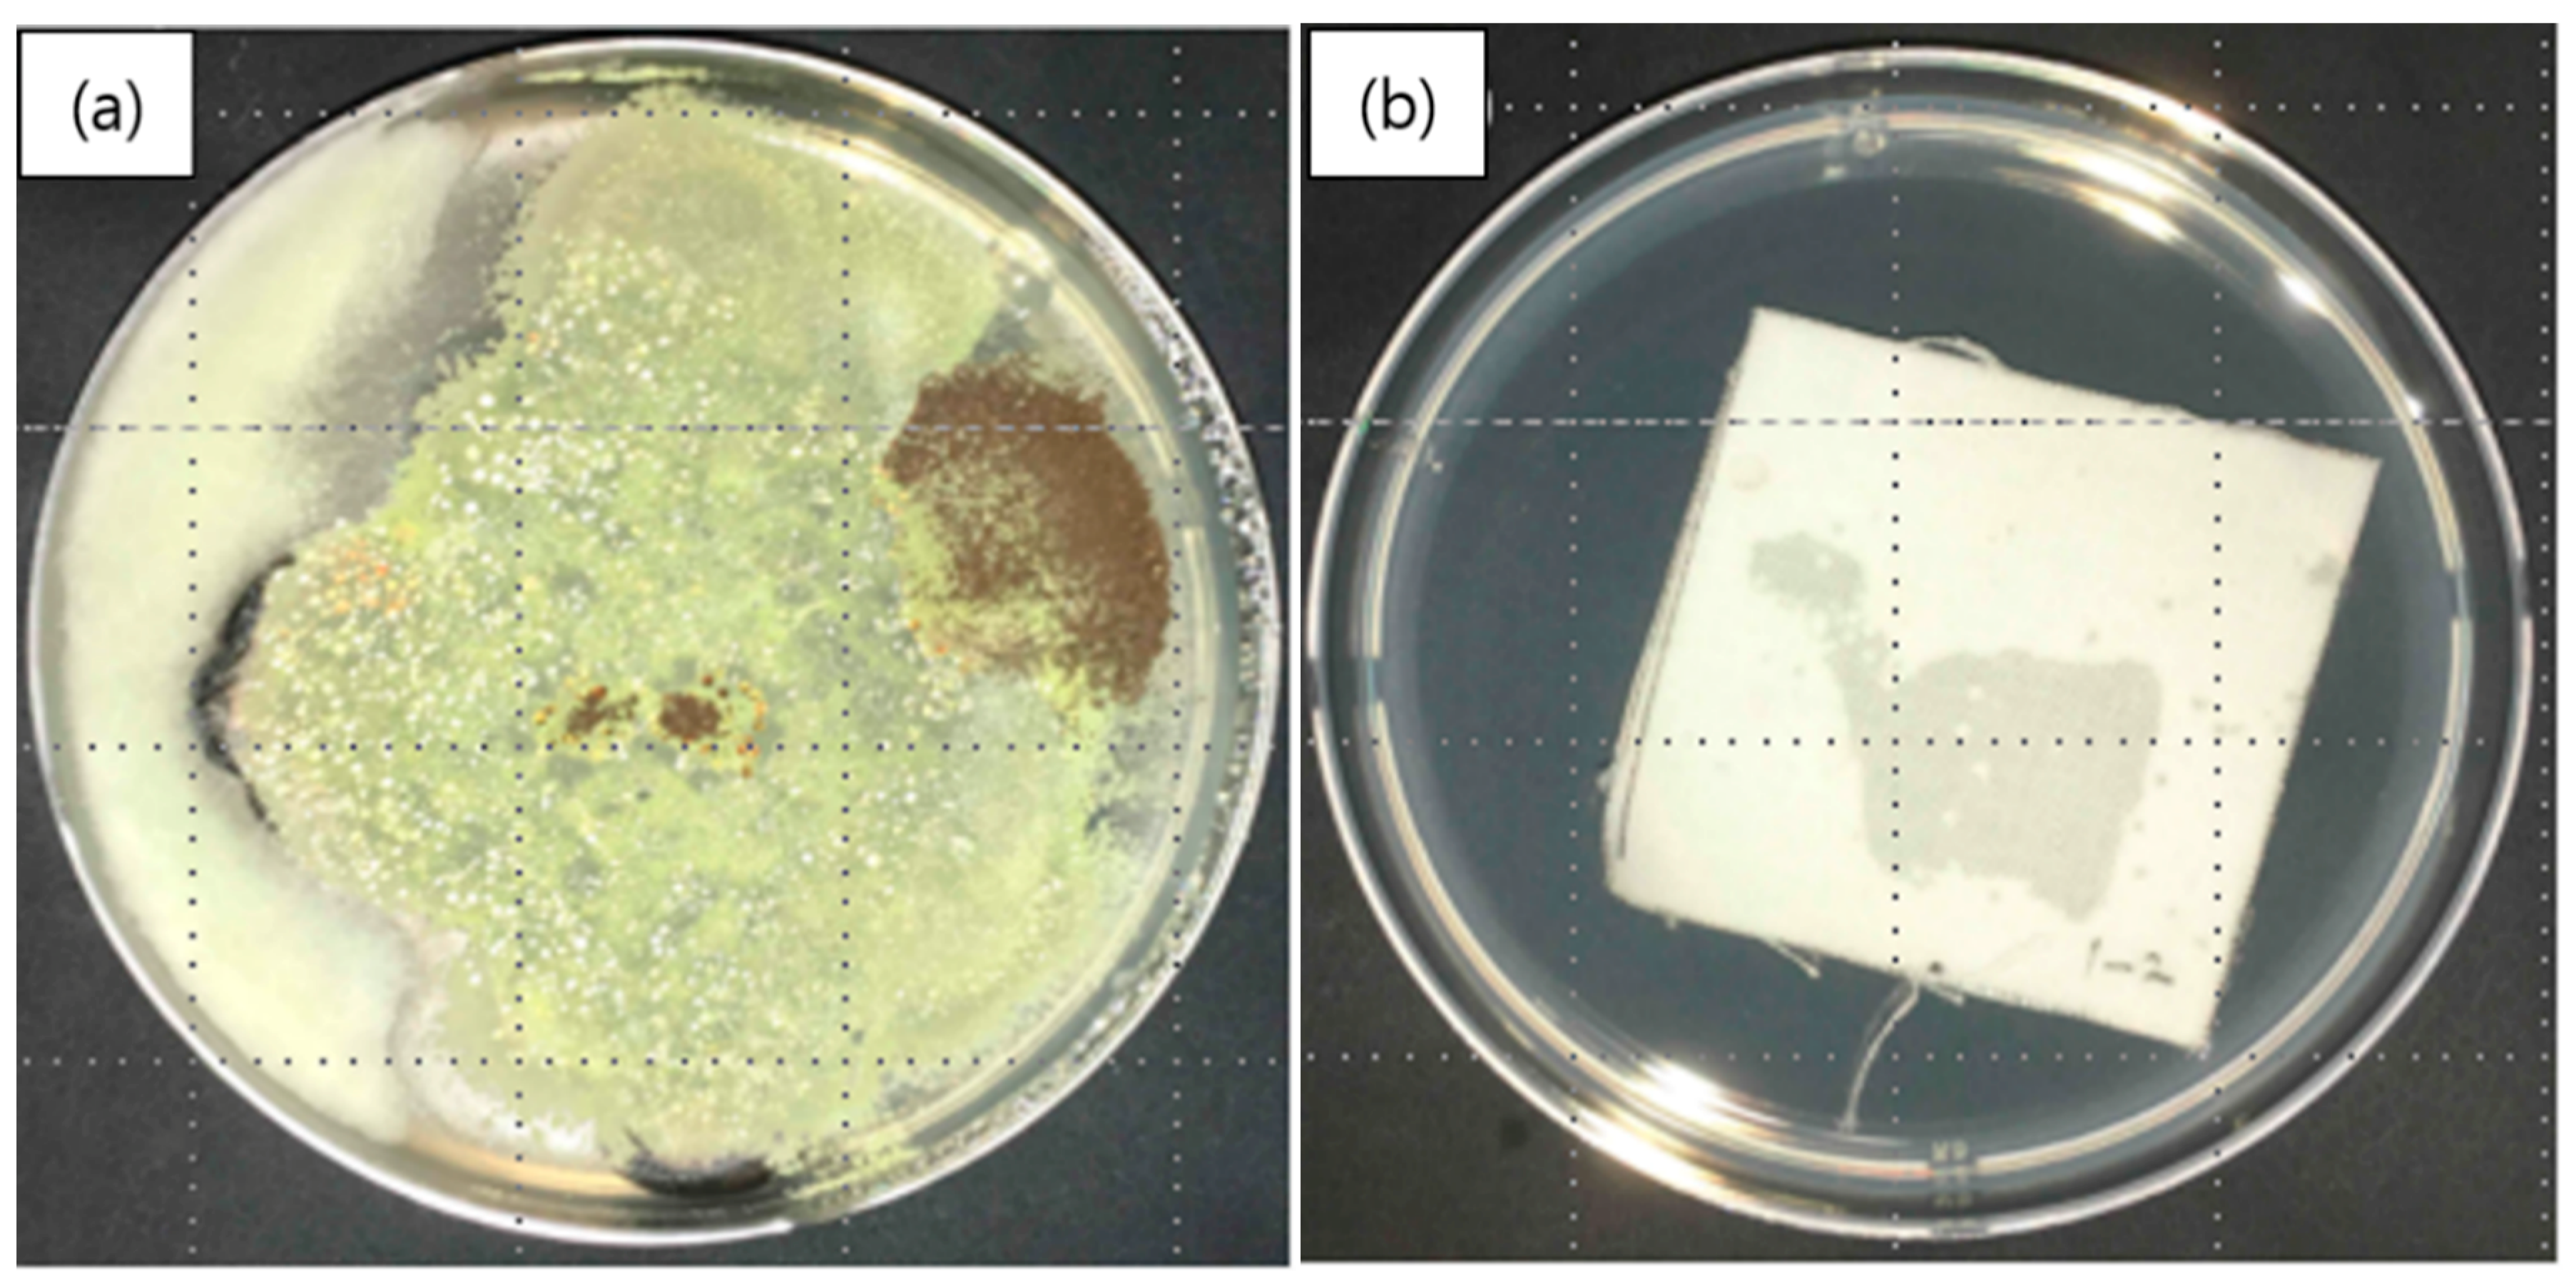
Polymers 12 00243 g008 Polymers 12 00243 g008

Core/Sheath-Structured Composite Nanofibers Containing Cinnamon Oil: Their Antibacterial and Antifungal Properties and Acaricidal Effect against House Dust Mites
Abstract
1. Introduction
2. Materials and Methods
2.1. Materials
2.2. Emulsion Preparation
2.3. Emulsion Electrospinning
2.4. Fiber Morphology
2.5. Assessment of the Acaricidal Effect of Nanocomposite Fibers against House Dust Mites
2.6. Antibacterial Activity
2.7. Antifungal Activity
2.8. Cinnamon Oil Release Studies
3. Results and Discussion
3.1. Fiber Morphology of Emulsion Electrospun Nanofibers
3.1.1. Composite Nanofibers Containing Low Concentrations of Cinnamon Oil
3.1.2. Composite Nanofibers Containing High Concentrations of Cinnamon Oil
3.2. Acaricidal Effects of Core/Sheath-Structured Nanofibers Containing Cinnamon Oil against House Dust Mites
3.3. Antibacterial Properties of Core/Sheath-Structured Nanofibers Containing Cinnamon Oil
3.4. Antifungal Properties of Core/Sheath-Structured Nanofibers Containing Cinnamon Oil
3.5. Release Behavior of Cinnamon Oil Emitted from Composite Nanofibers
4. Conclusions
Author Contributions
Funding
Conflicts of Interest
References
- Baldacci, S.; Maio, S.; Cerrai, S.; Sarno, G.; Baïz, N.; Simoni, M.; Annesi-Maesano, I.; Viegi, G. Allergy and asthma: Effects of the exposure to particulate matter and biological allergens. Respir. Med. 2015, 109, 1089–1104. [Google Scholar] [CrossRef]
- Bischoff, E.R.; Fischer, A.; Liebenberg, B.; Kniest, F.M. Mite control with low temperature washing-II. Elimination of living mites on clothing. Clin. Exp. Allergy 1998, 28, 60–65. [Google Scholar] [CrossRef] [PubMed]
- Nishioka, K.; Yasueda, H.; Saito, H. Preventive effect of bedding encasement with microfine fibers on mite sensitization. J. Allergy Clin. Immunol. 1998, 101, 28–32. [Google Scholar] [CrossRef]
- Shaaban, H.A.; El-Ghorab, A.H.; Shibamoto, T. Bioactivity of essential oils and their volatile aroma components. J. Essent. Oil Res. 2012, 24, 203–212. [Google Scholar] [CrossRef]
- Nerio, L.S.; Olivero-Verbel, J.; Stashenko, E. Repellent activity of essential oils: A review. Bioresour. Technol. 2010, 101, 372–378. [Google Scholar] [CrossRef]
- Khanna, S.; Chakraborty, J.N. Mosquito repellent activity of cotton functionalized with inclusion complexes of β-cyclodextrin citrate and essential oils. Fash. Text. 2018, 5, 9. [Google Scholar] [CrossRef]
- Ko, E.; Lee, H.; Han, C. Dyeability and functionality of wool fabrics dyed with Chamaecyparis obtusa leaf extract. J. Korean Soc. Cloth. Text. 2019, 43, 288–296. [Google Scholar] [CrossRef]
- Shin, J.; Lee, S. Encapsulation of phytoncide in nanofibers by emulsion electrospinning and their antimicrobial assessment. Fibers Polym. 2018, 19, 627–634. [Google Scholar] [CrossRef]
- Murbach Teles Andrade, B.F.; Nunes Barbosa, L.; Da Silva Probst, I.; Fernandes Júnior, A. Antimicrobial activity of essential oils. J. Essent. Oil Res. 2014, 26, 34–40. [Google Scholar] [CrossRef]
- Na, Y.E.; Kim, S.I.; Bang, H.S.; Kim, B.S.; Ahn, Y.J. Fumigant toxicity of cassia and cinnamon oils and cinnamaldehyde and structurally related compounds to Dermanyssus gallinae (Acari: Dermanyssidae). Vet. Parasitol. 2011, 178, 324–329. [Google Scholar] [CrossRef]
- Xu, X.; Zhuang, X.; Chen, X.; Wang, X.; Yang, L.; Jing, X. Preparation of core-sheath composite nanofibers by emulsion electrospinning. Macromol. Rapid Commun. 2006, 27, 1637–1642. [Google Scholar] [CrossRef]
- Angeles, M.; Cheng, H.L.; Velankar, S.S. Emulsion electrospinning: Composite fibers from drop breakup during electrospinning. Polym. Adv. Technol. 2008, 19, 728–733. [Google Scholar] [CrossRef]
- Su, Y.; Li, X.; Liu, S.; Mo, X.; Seeram, R. Controlled release of dual drugs from emulsion electrospun nanofibrous mats. Colloids Surf. B 2009, 73, 376–381. [Google Scholar]
- Wei, K.; Li, Y.; Mugishima, H.; Teramoto, A.; Abe, K. Fabrication of core-sheath structured fibers for model drug release and tissue engineering by emulsion electrospinning. Biotechnol. J. 2012, 7, 677–685. [Google Scholar] [CrossRef]
- Rieger, K.A.; Schiffman, J.D. Electrospinning an essential oil: Cinnamaldehyde enhances the antimicrobial efficacy of chitosan/poly(ethylene oxide) nanofibers. Carbohydr. Polym. 2014, 113, 561–568. [Google Scholar] [CrossRef]
- Wen, P.; Zhu, D.H.; Wu, H.; Zong, M.H.; Jing, Y.R.; Han, S.Y. Encapsulation of cinnamon essential oil in electrospun nanofibrous film for active food packaging. Food Control 2016, 59, 366–376. [Google Scholar] [CrossRef]
- Moon, K.W.; Byeon, S.H.; Choi, D.W.; Kim, Y.W.; Lee, J.H.; Lee, E.I. Exposure assessments on biological contaminants in homes of allergy patients-bacteria, fungi, house dust mite allergen and endotoxin. Korean J. Environ. Health Sci. 2005, 31, 120–126. [Google Scholar]
- ASTM. E 2149-13: Standard Test Method for Determining the Antimicrobial Activity of Antimicrobial Agents under Dynamic Contact Conditions; ASTM: West Conshohocken, PA, USA, 2001. [Google Scholar]
- ASTM. G 21-15: Standard Practice for Determining Resistance of Synthetic Polymeric Materials to Fungi; ASTM: West Conshohocken, PA, USA, 1987. [Google Scholar]
- Fong, H.; Chun, I.; Reneker, D.H. Beaded nanofibers formed during electrospinning. Polymer 1999, 40, 4585–4592. [Google Scholar] [CrossRef]
- Camerlo, A.; Vebert-Nardin, C.; Rossi, R.M.; Popa, A.M. Fragrance encapsulation in polymeric matrices by emulsion electrospinning. Eur. Polym. J. 2013, 49, 3806–3813. [Google Scholar] [CrossRef]
- Kim, H.K.; Kim, J.R.; Ahn, Y.J. Acaricidal activity of cinnamaldehyde and its congeners against Tyrophagus putrescentiae (Acari: Acaridae). J. Stored Prod. Res. 2004, 40, 55–63. [Google Scholar] [CrossRef]
- Hubert, J.; Münzbergová, Z.; Nesvorná, M.; Poltronieri, P.; Santino, A. Acaricidal effects of natural six-carbon and nine-carbon aldehydes on stored-product mites. Exp. Appl. Acarol. 2008, 44, 315–321. [Google Scholar] [CrossRef] [PubMed]
- Koul, O.; Walia, S.; Dhaliwal, G.S. Essential oils as green pesticides: Potential and constraints. Biopestic. Int. 2008, 4, 63–84. [Google Scholar]
- Stroh, J.; Wan, M.T.; Isman, M.B.; Moul, D.J. Evaluation of the acute toxicity to juvenile Pacific coho salmon and rainbow trout of some plant essential oils, a formulated product, and the carrier. Bull. Environ. Contam. Toxicol. 1998, 60, 923–930. [Google Scholar] [CrossRef] [PubMed]
- Wang, G.; Feng, H.; Hu, L.; Jin, W.; Hao, Q.; Gao, A.; Peng, X.; Li, W.; Wong, K.Y.; Wang, H.; et al. An antibacterial platform based on capacitive carbon-doped TiO2 nanotubes after direct or alternating current charging. Nat. Commun. 2018, 9, 2055. [Google Scholar] [CrossRef]
- Tian, J.; Feng, H.; Yan, L.; Yu, M.; Ouyang, H.; Li, H.; Jiang, W.; Jin, Y.; Zhu, G.; Li, Z.; et al. A self-powered sterilization system with both instant and sustainable anti-bacterial ability. Nano Energy 2017, 36, 241–249. [Google Scholar] [CrossRef]
- Gotmare, V.D.; Kole, S.S.; Athawale, R.B. Sustainable approach for development of antimicrobial textile material using nanoemulsion for wound care applications. Fash. Text. 2018, 5, 25. [Google Scholar] [CrossRef]
- Jeong, J.; Lee, S. Electrospun poly(vinyl alcohol) nanofibrous membranes containing Coptidis Rhizoma extracts for potential biomedical applications. Text. Res. J. 2019, 89, 3506–3518. [Google Scholar] [CrossRef]
- Kim, J.; Lee, J. Characterization of electrospun Juniperus Chinensis extracts loaded PU nanoweb. J. Korean Soc. Cloth. Text. 2017, 41, 131–140. [Google Scholar] [CrossRef]
- Jarlier, V.; Nikaido, H. Mycobacterial cell wall: Structure and role in natural resistance to antibiotics. FEMS Microbiol. Lett. 1994, 123, 11–18. [Google Scholar] [CrossRef]
- Singh, G.; Maurya, S.; DeLampasona, M.P.; Catalan, C.A. A comparison of chemical, antioxidant and antimicrobial studies of cinnamon leaf and bark volatile oils, oleoresins and their constituents. Food Chem. Toxicol. 2007, 45, 1650–1661. [Google Scholar] [CrossRef]
- El-Zemity, S.R.; Rezk, H.A.; Farok, S.; Zaitoon, A.A. Acaricidal activity of some essential oils and their monoterpenoidal constituents against the house dust mite, Dermatophagoides pteronyssinus (Acari: Pyroglyphidae). In Trends in Acarology; Springer: Dordrecht, The Netherlands, 2010; pp. 541–543. [Google Scholar]
- Perrucci, S. Acaricidal activity of some essential oils and their constituents against Tyrophagus longior, a mite of stored food. J. Food Prot. 1995, 58, 560–563. [Google Scholar] [CrossRef] [PubMed]
- Sánchez-Ramos, I.; Castañera, P. Acaricidal activity of natural monoterpenes on Tyrophagus putrescentiae (Schrank), a mite of stored food. J. Stored Prod. Res. 2000, 37, 93–101. [Google Scholar] [CrossRef]
- Son, Y.S.; Lim, B.A.; Park, H.J.; Kim, J.C. Characteristics of volatile organic compounds (VOCs) emitted from building materials to improve indoor air quality: Focused on natural VOCs. Air Qual. Atmos. Health 2013, 6, 737–746. [Google Scholar] [CrossRef]

| Emulsion | Concentration (wt%) | ||
|---|---|---|---|
| PVA | Cinnamon Oil | Surfactant | |
| A | 10 | 3.57 | 0.71 |
| B | 11 | 3.93 | 0.79 |
| C | 12 | 4.29 | 0.86 |
| D | 13 | 4.64 | 0.93 |
| E | 14 | 5 | 1 |
| Emulsion | Concentration (wt%) | ||
|---|---|---|---|
| PVA | Cinnamon Oil | Surfactant | |
| C | 12 | 4.29 | 0.86 |
| F | 8 | 1.6 | |
| G | 15 | 3 | |
| H | 20 | 4 | |
| I | 30 | 6 | |
| Observed Growth on Specimens | Rating |
|---|---|
| No growth | 0 |
| Trace of growth (less than 10% coverage) | 1 |
| Slight growth (10%–30% coverage) | 2 |
| Moderate growth (30%–60% coverage) | 3 |
| Heavy growth (60%–100% coverage) | 4 |
| Sample | Sample Condition | Oil Concentration in Emulsion | Acaricidal Effect (Dead/Alive) | |
|---|---|---|---|---|
| Start | 1 h | |||
| Nanofibrous membranes containing cinnamon oil | As-spun | 4.29 wt% (emulsion C) | 0/30 | 0/30 |
| 8 wt% (emulsion F) | ||||
| 15 wt% (emulsion G) | ||||
| 20 wt% (emulsion H) | 0/30 | 30/0 | ||
| 30 wt% (emulsion I) | ||||
| Dried | 4.29 wt% (emulsion C) | 0/30 | 0/30 | |
| 8 wt% (emulsion F) | ||||
| 15 wt% (emulsion G) | ||||
| 20 wt% (emulsion H) | ||||
| 30 wt% (emulsion I) | ||||
| Control | As-spun | - | 0/30 | 0/30 |
| Dried | - | 0/30 | 0/30 | |
| Contact Time (h) | Number of Bacterial Colonies (CFU/mL) | Bacterial Reduction (%) | ||
|---|---|---|---|---|
| Control | Nanofibrous Membranes Containing Cinnamon Oil | |||
| Staphylococcus aureus | 0 | 2.5 × 105 | 2.5 × 105 | - |
| 24 | 1.3 × 105 | 9.0 × 10 | 99.9 | |
| Klebsiella pneumoniae | 0 | 2.1 × 105 | 2.1 × 105 | - |
| 24 | 1.7 × 105 | 3.0 × 105 | 0 | |
| Emulsion (Oil Concentration) | Testing Period | Total VOC a (μg/m3) | Natural VOC a (μg/m3) | Major Chemical Component | Natural VOC a (%) | ||
|---|---|---|---|---|---|---|---|
| Cinnamaldehyde (μg/m3) | Eugenol (μg/m3) | Caryophyllene (μg/m3) | |||||
| Emulsion H (20 wt%) | Day 0 | 37360.0 | 24671.9 | 20063.4 | 7448.8 | 5677.4 | 65.9 |
| Emulsion C (4.29 wt%) | Day 0 | 1379.8 | 461.5 | 362.7 | 73.6 | 44.3 | 35.0 |
| Day 7 | 723.2 | 59.5 | 36.3 | 16.0 | 9.9 | 8.8 | |
| Day 14 | 489.8 | 68.2 | 37.5 | 2.1 | 8.6 | 13.5 | |
| Day 21 | 746.0 | 100.4 | 41.3 | 9.6 | 9.0 | 13.1 | |
| Day 28 | 291.3 | 32.4 | 18.0 | 3.1 | 5.5 | 11.4 | |
© 2020 by the authors. Licensee MDPI, Basel, Switzerland. This article is an open access article distributed under the terms and conditions of the Creative Commons Attribution (CC BY) license (http://creativecommons.org/licenses/by/4.0/).
Share and Cite
Jung, Y.; Yang, H.; Lee, I.-Y.; Yong, T.-S.; Lee, S. Core/Sheath-Structured Composite Nanofibers Containing Cinnamon Oil: Their Antibacterial and Antifungal Properties and Acaricidal Effect against House Dust Mites. Polymers 2020, 12, 243. https://doi.org/10.3390/polym12010243
Jung Y, Yang H, Lee I-Y, Yong T-S, Lee S. Core/Sheath-Structured Composite Nanofibers Containing Cinnamon Oil: Their Antibacterial and Antifungal Properties and Acaricidal Effect against House Dust Mites. Polymers. 2020; 12(1):243. https://doi.org/10.3390/polym12010243
Chicago/Turabian StyleJung, Yoonwon, Hyukjoo Yang, In-Yong Lee, Tai-Soon Yong, and Seungsin Lee. 2020. "Core/Sheath-Structured Composite Nanofibers Containing Cinnamon Oil: Their Antibacterial and Antifungal Properties and Acaricidal Effect against House Dust Mites" Polymers 12, no. 1: 243. https://doi.org/10.3390/polym12010243
APA StyleJung, Y., Yang, H., Lee, I.-Y., Yong, T.-S., & Lee, S. (2020). Core/Sheath-Structured Composite Nanofibers Containing Cinnamon Oil: Their Antibacterial and Antifungal Properties and Acaricidal Effect against House Dust Mites. Polymers, 12(1), 243. https://doi.org/10.3390/polym12010243

